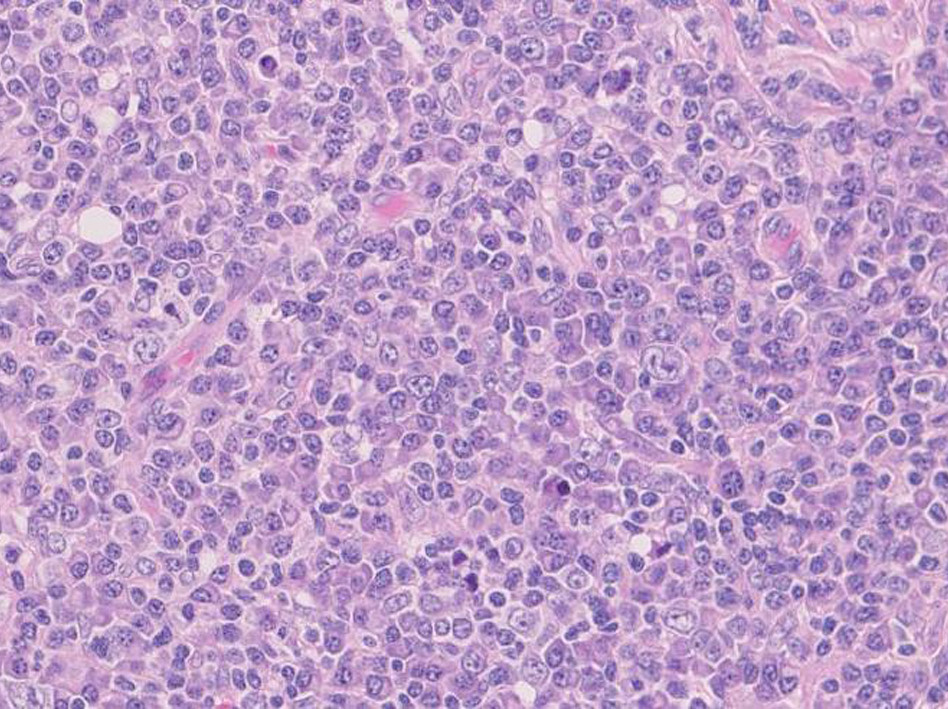

![[PukiWiki] [PukiWiki]](image/title-logo.png)
50歳代 男性
一年ほど前, 顎下腫瘤を自覚. 健康診断で貧血, 蛋白尿を指摘され内科受診. 耳鼻咽喉科では両側顎下腺と頸部リンパ節腫大, 右咽頭部腫瘤を指摘される. 吸引針生検では悪性所見は認められず. sIL-2R高値. PET-CTで両顎下腺などに高集積域あり. 悪性リンパ腫が疑われた。
病理診断:IgG4関連硬化症リンパ節病変
■Virtual Slide--->頸部リンパ節 右クリックで新しいウィンドウで開くと便利です。Sign as guestでログインして下さい。
胚中心を伴うリンパ濾胞が散在し濾胞間に形質細胞が密に集簇して認められる。形質細胞系細胞はIgG陽性でkappa, lambda染色よりpolyclonalと考えられた。IgG陽性細胞の60-70%はIgG4陽性。リンパ濾胞内にIgG4産生細胞が散在していた。
IgG4関連硬化性疾患の臨床的特徴--本症例は1-4の特徴に一致する。
IgG4関連硬化性疾患の病理学的特徴
IgG4